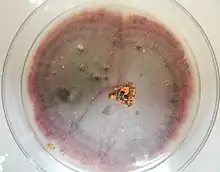

| Colletotrichum fioriniae | |
|---|---|
| |
| Scientific classification | |
| Kingdom: | |
| Division: | |
| Class: | |
| Order: | |
| Family: | |
| Genus: | |
| Species complex: | |
| Species: | C. fioriniae |
| Binomial name | |
| Colletotrichum fioriniae Marcelino & Gouli (2008) | |
Colletotrichum fioriniae is a fungal plant pathogen and endophyte of fruits and foliage of many broadleaved plants worldwide.[1][2] It causes diseases on agriculturally important crops, including anthracnose of strawberry, ripe rot of grapes, bitter rot of apple, anthracnose of peach, and anthracnose of blueberry.[3] Its ecological role in the natural environment is less well understood, other than it is a common leaf endophyte of many temperate trees and shrubs[2] and in some cases may function as an entomopathogen.[4]
Taxonomic history
C. fioriniae was formally described as a variety of Colletotrichum acutatum in 2008,[4] and as its own species shortly thereafter.[5] However, while it had not previously been recognized as a separate species, when grown on potato dextrose agar it produces a distinct pink to maroon red color on the bottom side and was described in historical studies as "chromogenic" isolates of Glomerella cingulata.[6][7][8] It is currently recognized as a species within the C. acutatum species complex.[1]
Identification
C. fioriniae produces conidia that are smooth-walled, hyaline (glassy and translucent), with acute (pointed) ends, measuring about 15 x 4.5 microns.[1] When grown on potato dextrose agar it usually produces a pink to dark red chromogenic color on the reverse side. However, these morphological characteristic overlap with those of other species in the C. acutatum species complex, so definitive identification requires the sequencing of DNA barcoding regions such as the internally transcribed spacer (ITS), or introns in the GAPDH, histone3, beta-tubulin, or actin genes.[9]
Reproduction
Like other species in the C. acutatum species complex, C. fioriniae reproduces almost exclusively via the production of asexual spores called conidia.[10][1] These conidia are often produced in sticky gelatinous orange masses that are rain-splash dispersed.[10][11] Conidia are mostly produced at temperatures from 10 to 30 °C, such that in temperate deciduous forests and orchards rain-splash dispersal occurs from bud-break to leaf drop.[12]
Pathogenic lifestyle
As a plant pathogen, C. fioriniae has a hemibiotrophic lifestyle, where infections are initially biotrophic (or latent or quiescent, depending on the point of view) before switching to necrotrophy and active killing of the plant cells.[10]
References
- 1 2 3 4 Damm, U.; Cannon, P.F.; Woudenberg, J.H.C.; Crous, P.W. (2012). "The Colletotrichum acutatum species complex". Studies in Mycology. 73 (1): 37–113. doi:10.3114/sim0010. PMC 3458416. PMID 23136458.
- 1 2 Martin, Phillip L.; Peter, Kari A. (2021). "Quantification of Colletotrichum fioriniae in Orchards and Deciduous Forests Indicates It Is Primarily a Leaf Endophyte". Phytopathology. 111 (2): 333–344. doi:10.1094/PHYTO-05-20-0157-R. ISSN 0031-949X. PMID 32729787. S2CID 220875296.
- ↑ Dowling, Madeline; Peres, Natalia; Villani, Sara; Schnabel, Guido (2020). "Managing Colletotrichum on Fruit Crops: A "Complex" Challenge". Plant Disease. 104 (9): 2301–2316. doi:10.1094/PDIS-11-19-2378-FE. ISSN 0191-2917. PMID 32689886. S2CID 219479598.
- 1 2 Marcelino, Jose; Giordano, Rosanna; Gouli, Svetlana; Gouli, Vladimir; Parker, Bruce L.; Skinner, Margaret; TeBeest, David; Cesnik, Roberto (2008). "Colletotrichum acutatum var. fioriniae (teleomorph: Glomerella acutata var. fioriniae var. nov.) infection of a scale insect". Mycologia. 100 (3): 353–374. doi:10.3852/07-174R. ISSN 0027-5514. PMID 18751543. S2CID 8465617.
- ↑ Shivas, R.G.* and Tan, Y.P. (2009). "A taxonomic re-assessment of Colletotrichum acutatum, introducing C. fioriniae comb. et stat. nov. and C. simmondsii sp. nov" (PDF). Fungal Diversity. 39: 111–122.
{{cite journal}}: CS1 maint: multiple names: authors list (link) - ↑ Struble, F. Ben; Keitt, G. W. (1950). "Variability and Inheritance in Glomerella cingulata (Stonem.) S. and V. S. from Apple". American Journal of Botany. 37 (8): 563–576. doi:10.1002/j.1537-2197.1950.tb11045.x. ISSN 0002-9122.
- ↑ Shane, W. W. (1981). "Germination, Appressorium Formation, and Infection of Immature and Mature Apple Fruit byGlomerella cingulata". Phytopathology. 71 (4): 454. doi:10.1094/phyto-71-454. ISSN 0031-949X.
- ↑ Latham, A. J.; Williams, J. C. (1983). "Cultural Characteristics and Pathogenicity of Glomerella cingulata Isolates from Apples in Alabama". Plant Disease. 67 (10): 1065. doi:10.1094/PD-67-1065. ISSN 0191-2917.
- ↑ Vieira, Willie Anderson dos Santos; Bezerra, Priscila Alves; Silva, Anthony Carlos da; Veloso, Josiene Silva; Câmara, Marcos Paz Saraiva; Doyle, Vinson Patrick (2020). "Optimal markers for the identification of Colletotrichum species". Molecular Phylogenetics and Evolution. 143: 106694. doi:10.1016/j.ympev.2019.106694. PMID 31786239. S2CID 208537507.
- 1 2 3 Peres, N. A.; Timmer, L. W.; Adaskaveg, J. E.; Correll, J. C. (2005). "Lifestyles of Colletotrichum acutatum". Plant Disease. 89 (8): 784–796. doi:10.1094/PD-89-0784. ISSN 0191-2917. PMID 30786507.
- ↑ Wharton, Phillip S., and Javier Diéguez-Uribeondo (2004). "The biology of Colletotrichum acutatum". Anales del Jardín Botánico de Madrid. 61: 3–22. doi:10.3989/ajbm.2004.v61.i1.61.
{{cite journal}}: CS1 maint: multiple names: authors list (link) - ↑ Martin, Phillip L.; Peter, Kari (2023). "Spore dispersal patterns of Colletotrichum fioriniae in orchards and the timing of apple bitter rot infection periods". Plant Disease. doi:10.1094/PDIS-08-22-1966-RE. ISSN 0191-2917.
Further reading
- Suppl. T 1 & 2 — Taxonomy, taxonomic IDs, 14 predicted proteins:
- Seidl, Michael F.; Van den Ackerveken, Guido (2019-08-25). "Activity and Phylogenetics of the Broadly Occurring Family of Microbial Nep1-Like Proteins". Annual Review of Phytopathology. Annual Reviews. 57 (1): 367–386. doi:10.1146/annurev-phyto-082718-100054. ISSN 0066-4286. PMID 31283435. S2CID 195843955.